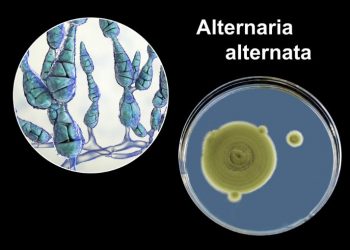
Alternaria Symptoms

Home
Cows Milk Allergy
Cows milk allergy symptoms can be quite serious. A person suffering from this condition can suffer from diarrhea, bloating, abdominal...
Read moreDetailsVenom Allergy
Venom allergy symptoms are caused by the interaction of venom and a certain type of antibody called IgE. People who...
Read moreDetailsInsulin Allergy
Insulin allergy is a rare but serious condition. It can cause a rash, swelling or itching at the injection site....
Read moreDetailsAll About Allergy Symptoms
Allergy symptoms are caused by a reaction that the immune system has against a substance. Allergy symptoms can range from...
Read moreDetailsAlzheimer’s Disease Symptoms
Alzheimer's disease symptoms may include memory loss, difficulty with everyday tasks, mood changes, and changes in behavior. Symptoms vary from...
Read moreDetailsRecognizing Alcoholism Problems
Alcoholism is a serious problem, and it can have a huge impact on a person's life. When you recognize some...
Read moreDetailsAlternaria Symptoms
Alternaria is a common fungal genus that affects many crops. They can affect seeds, weeds, and garden vegetables. They are...
Read moreDetailsSepsis Symptoms and Treatment
Sepsis is a serious medical condition that develops as a result of an infection. It can occur in a number...
Read moreDetailsAgnosia Treatment
Agnosia is a neurological disorder that is characterized by the lack of recognition of sensory stimuli, such as sight, sound,...
Read moreDetailsAldosteronism Symptoms
Aldosteronism is a medical condition that causes an imbalance in the amounts of sodium, potassium, and fluid in the body....
Read moreDetails